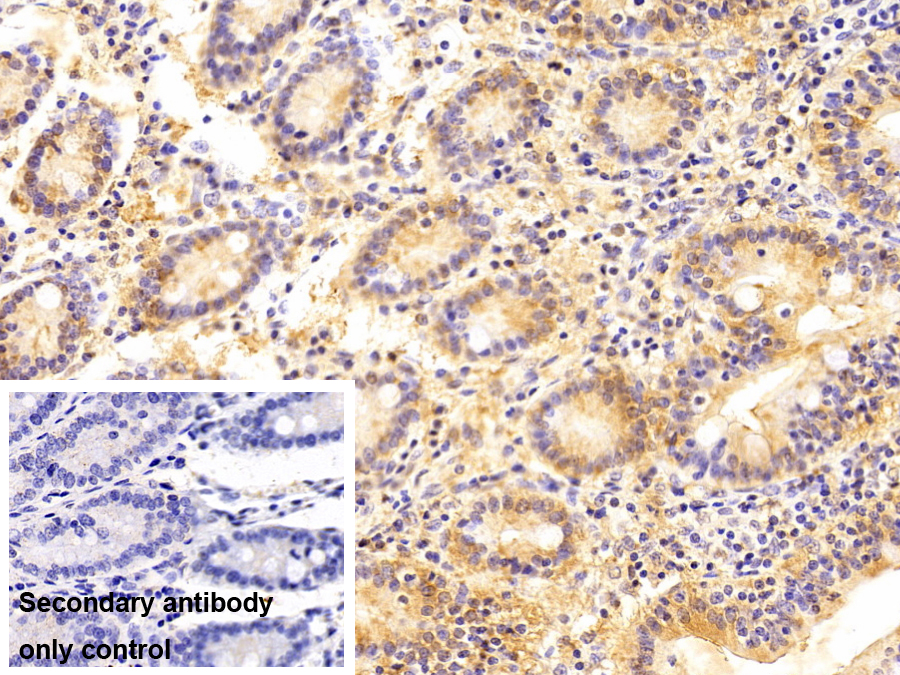
二氫二醇脫氫酶2(DDH2)多克隆抗體

二氫二醇脫氫酶2(DDH2)多克隆抗體
Polyclonal Antibody to Dihydrodiol Dehydrogenase 2 (DDH2)
AKR1C2; DD; BABP; DD2; HAKRD; MCDR2; Aldo-Keto Reductase Family 1,Member C2; Bile Acid Binding Protein; 3-Alpha Hydroxysteroid Dehydrogenase Type III
- 編號(hào)PAQ200Hu01
- 物種Homo sapiens (Human,人)相同的名稱,不同的物種。
- 來(lái)源多抗制備
- 宿主兔
- 效價(jià)-
- Ig類型IgG
- 純化方式抗原特異性親和純化
- 標(biāo)記物無(wú)標(biāo)記物
- 免疫原RPQ200Hu01-二氫二醇脫氫酶2(DDH2)重組蛋白
- 緩沖液成份0.01M 磷酸鹽緩沖液(pH7.4,containing 0.05% Proclin-300,50% glycerol)
- 性狀液體
- 濃度0.5mg/mL
- 且適物種Sus scrofa; Porcine (Pig,豬)
- 應(yīng)用WB,IHC
如果抗體需用于流式細(xì)胞術(shù),請(qǐng)參見流式抗體。 - 下載英文說(shuō)明書 中文說(shuō)明書
- 規(guī)格20μl100μl200μl1ml10ml
- 價(jià)格¥ 695¥ 1621¥ 2316¥ 5790¥ 23160
- 欲了解實(shí)際交易價(jià)格和更多情況,請(qǐng)與當(dāng)?shù)亟?jīng)銷商聯(lián)系!
特異性
該抗體是針對(duì)DDH2的兔多克隆抗體。在免疫組織化學(xué)染色和免疫印跡實(shí)驗(yàn)中能識(shí)別DDH2。
用法
Western blotting: 0.01-2μg/mL;
Immunohistochemistry: 5-20μg/mL;
Optimal working dilutions must be determined by end user.
儲(chǔ)存
經(jīng)常使用則4°C保存。-20°C保存不超過(guò)兩年。避免反復(fù)凍融。
穩(wěn)定性
熱穩(wěn)定性以損失率顯示。損失率是由加速降解試驗(yàn)決定,具體方法如下:在37°C孵育48小時(shí),沒有顯著的降解或者沉淀產(chǎn)生。保質(zhì)期內(nèi),在適當(dāng)?shù)臈l件下存儲(chǔ),損失率低于5%。
贈(zèng)品
增值服務(wù)
抗體標(biāo)記定制服務(wù)
Protein-A/G純化柱
細(xì)胞和組織染色液
抗體陽(yáng)性對(duì)照品
組織/切片定制服務(wù)
磷酸化抗體定制服務(wù)
免疫印跡(WB)實(shí)驗(yàn)服務(wù)
免疫組織化學(xué)(IHC)實(shí)驗(yàn)服務(wù)
免疫細(xì)胞化學(xué)(ICC)實(shí)驗(yàn)服務(wù)
流式細(xì)胞術(shù)(FCM)實(shí)驗(yàn)服務(wù)
免疫沉淀(IP)實(shí)驗(yàn)服務(wù)
免疫熒光(IF)實(shí)驗(yàn)服務(wù)
緩沖液
DAB顯色試劑盒
SABC試劑盒
長(zhǎng)臂生物素標(biāo)記試劑盒
實(shí)時(shí)熒光定量PCR實(shí)驗(yàn)服務(wù)
相關(guān)產(chǎn)品
| 編號(hào) | 適用物種:Homo sapiens (Human,人) | 應(yīng)用(僅供研究使用,不用于臨床診斷!) |
| RPQ200Hu01 | 二氫二醇脫氫酶2(DDH2)重組蛋白 | Positive Control; Immunogen; SDS-PAGE; WB. |
| PAQ200Hu01 | 二氫二醇脫氫酶2(DDH2)多克隆抗體 | WB,IHC |
| MAQ200Hu21 | 二氫二醇脫氫酶2(DDH2)單克隆抗體 | WB; IHC; ICC; IP. |
| SEQ200Hu | 二氫二醇脫氫酶2(DDH2)檢測(cè)試劑盒(酶聯(lián)免疫吸附試驗(yàn)法) | Enzyme-linked immunosorbent assay for Antigen Detection. |
| LMQ200Hu | 二氫二醇脫氫酶2(DDH2)等多因子檢測(cè)試劑盒(流式熒光發(fā)光法) | FLIA Kit for Antigen Detection. |
參考文獻(xiàn)
| 雜志 | 參考文獻(xiàn) |
| Lung Cancer | Proteomics-based identification of secreted protein dihydrodiol dehydrogenase 2 as a potential biomarker for predicting cisplatin efficacy in advanced NSCLC patients[ScienceDirect: S0169500212001274] |
| Clinical and Experimental Optometry | Aldo-keto reductase and sorbitol dehydrogenase enzymes in Egyptian diabetic patients with and without proliferative diabetic retinopathy.[Pubmed: 23452182] |